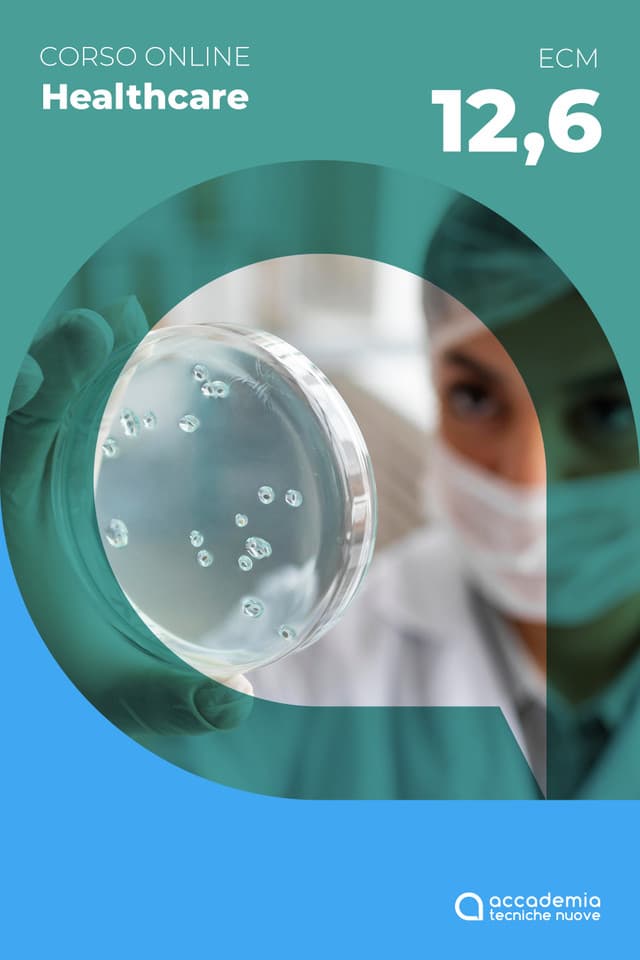
Antimicrobico-resistenza: corretto uso degli antibiotici, test rapidi e appropriatezza prescrittiva

Tutti i CorsiAntimicrobico-resistenza: corretto uso degli antibiotici, test rapidi e appropriatezza prescrittiva

Antimicrobico-resistenza: corretto uso degli antibiotici, test rapidi e appropriatezza prescrittiva
79,00 €
o 3 rate da 26,33€ senza interessi.
Disponibilità immediata
ATTENZIONE:ogni corso può essere svolto una sola volta ai fini dell’aggiornamento e non deve essere acquistato più volte.
In sintesi
- Destinatari:Igienisti dentali, Tutte le professioni sanitarie
- Modalità:Online
- ID ECM:439240
- Obiettivo Formativo:20
- Data inizio:03/02/2025
- Durata:7
- Attestato rilasciato:Attestato ECM
- Da fruire entro:31/12/2025
- Crediti:12,6